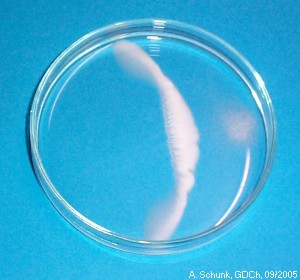
Experiment des Monats

|
Experiment des Monats
|
Fällungsreaktionen werden meist in Reagenzgläsern gezeigt, wobei die beiden Reagenzien als wässrige Lösungen zusammengegeben werden. Die Durchführung in einer Petrischale ermöglicht einen etwas anderen Blick auf die Reaktion, wobei Strukturbildungen beobachtet werden können.
|
 |
Geräte und Chemikalien:
Silbernitrat,
Kochsalz,
Kaliumiodid
Petrischale.
Durchführung:
Eine Petrischale wird zur Hälfte mit Wasser gefüllt.
Auf einer Seite wird eine Spatelspitze NaCl zugegeben, auf der entgegengesetzten
Seite der Schale eine Spatelspitze AgNO3. (Die Zugabe sollte in dieser
Reihenfolge erfolgen, da sich AgNO3 erheblich schneller löst.)
Nach kurzer Zeit bildet sich etwa in der Mitte der Schale ein bogenförmiger
weißer Niederschlag. Dabei treten interessante Strukturen auf.
Wird statt NaCl KI verwendet, ergibt sich eine gelbe Fällung.
Der Versuch ist zur Projektion mit einem Tageslichtprojektor geeignet.
Erklärung:
Silberionen bilden mit Halogenid-Ionen schwerlösliche Niederschläge:
Ag+ + Cl–  AgCl ¯ (weiß)
AgCl ¯ (weiß)
Ag+ + Br–  AgBr ¯ (hellgelb)
AgBr ¯ (hellgelb)
Ag+ + I –  AgI ¯ (gelb)
AgI ¯ (gelb)
Die Salze lösen sich und verteilen sich durch Diffusion in der Schale.
Sobald die verschiedenen Lösungen aufeinander treffen, tritt der Niederschlag auf.
Die Strukturen entstehen durch Diffusions- und Konvektionseffekte.
Entsorgung:
Die Lösungen kommen zum Schwermetallabfall.
Literatur & Links:
Lutz Stäudel: "Reaktionen in der Petrischale",
Naturwissenschaften im Unterricht - Chemie,
16 (2005), 543-544
August 2005: Das Gummibärchenbad
 zurück zum aktuellen Experiment
zurück zum aktuellen Experiment
Seite erstellt am: Mittwoch, 31. August 2005, A. Schunk, GDCh, Frankfurt/Main.
Für den Inhalt externer Seiten wird keine Verantwortung übernommen!